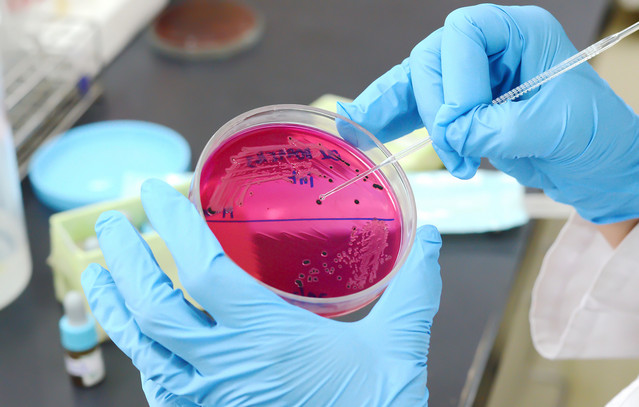
Σαλμονέλα-σε-αμφιλεγόμενο-τρόφιμο-μόλυνε-160-ανθρώπους

Σαλμονέλα σε αμφιλεγόμενο τρόφιμο μόλυνε 160 ανθρώπους
Ένας νέος αποκαλυπτικός απολογισμός αναδεικνύει το σοκαριστικό εύρος μιας επιδημίας σαλμονέλας που σχετίζεται με προϊόντα ωμού γάλακτος.
Σύμφωνα με την αναφορά που δημοσιεύτηκε στο Morbidity and Mortality Weekly Report από τα Κέντρα Ελέγχου και Πρόληψης Νοσημάτων (CDC), η επιδημία σημειώθηκε μεταξύ Σεπτεμβρίου 2023 και Μαρτίου 2024 και επηρέασε περισσότερα από 160 άτομα.
Οι συντάκτες της έκθεσης επισήμαναν ότι το μέγεθος της νόσου καθιστά την περίπτωση στην Καλιφόρνια «μία από τις μεγαλύτερες επιδημίες τροφικής προέλευσης συνδεδεμένες με ωμό γάλα στη σύγχρονη ιστορία των ΗΠΑ».
Το ωμό γάλα είναι γάλα που δεν έχει παστεριωθεί, δηλαδή δεν έχει υποβληθεί σε θερμοκρασίες ικανές να καταστρέψουν πιθανώς επικίνδυνα μικρόβια.
Το Υπουργείο Δημόσιας Υγείας της Καλιφόρνια ενημερώθηκε πρώτα για το πρόβλημα όταν εννέα άτομα ανέφεραν συμπτώματα μετά την κατανάλωση προϊόντων ωμού γάλακτος από την ίδια γαλακτοκομική μονάδα, γεγονός που οδήγησε σε έρευνα από τις κρατικές και ομοσπονδιακές αρχές.
Η επιδημία του προηγούμενου έτους επηρέασε δυσανάλογα τα μικρά παιδιά, με μέση ηλικία τα 7 έτη, γεγονός ιδιαίτερα ανησυχητικό αφού τα παιδιά είναι πιο ευάλωτα στον παθογόνο παράγοντα.
Σύμφωνα με τον FDA, τα συμπτώματα της νόσου εμφανίζονται συνήθως 12 έως 72 ώρες μετά την κατανάλωση τροφής μολυσμένης με βακτήρια σαλμονέλας. Τα συμπτώματα περιλαμβάνουν διάρροια, πυρετό και κοιλιακούς πόνους και μπορεί να είναι πολύ πιο σοβαρά για παιδιά κάτω των πέντε ετών, ηλικιωμένους και άτομα με εξασθενημένο ανοσοποιητικό σύστημα.
Σε ορισμένες σοβαρές περιπτώσεις, η σαλμονέλα μπορεί να επεκταθεί πέρα από το πεπτικό σύστημα και να εισβάλλει στο αίμα, τον εγκέφαλο, τα οστά και τις αρθρώσεις.
Η έκθεση προειδοποιεί ότι «τα προϊόντα ωμού γάλακτος που διανέμονται εμπορικά έχουν τη δυνατότητα να προκαλέσουν μεγάλες και εκτεταμένες επιδημίες μολυσματικών ασθενειών».
Στην τελευταία επιδημία, το 70% των κρουσμάτων αφορούσε παιδιά και εφήβους: 67 περιστατικά καταγράφηκαν σε παιδιά κάτω των 5 ετών, 40 σε παιδιά ηλικίας 5 έως 12 ετών και 13 σε εφήβους κάτω των 18 ετών.
Παρά το γεγονός ότι δεν αναφέρθηκαν θάνατοι, 22 περιστατικά κατέληξαν σε νοσηλεία, εκ των οποίων τα 18 αφορούσαν ανηλίκους κάτω των 18 ετών.
Προηγουμένως, οι επιδημίες σαλμονέλας συνδεδεμένες με ωμό γάλα ήταν σχετικά σπάνιες σε αριθμό και έκταση. Μεταξύ 2009 και 2021, καταγράφηκαν 16 επιδημίες που αφορούσαν ωμό γάλα, με αριθμό προσβεβλημένων από 2 έως 33 άτομα.
Η μόλυνση μπορεί να συμβεί σε διάφορα στάδια της διαδικασίας αρμέγματος, καθώς τα βακτήρια μπορούν να βρεθούν από τους μαστούς της αγελάδας έως τα χέρια του αγρότη.
Εκτός από τη σαλμονέλα, το ωμό γάλα μπορεί να φέρει ή να περιέχει ιούς γρίπης των πτηνών, λιστέρια, E.coli, καμπυλοβακτήριο, κρυπτοσπορίδιο και βρουκέλλα.
Για τα παιδιά κάτω των 5 ετών, τις εγκύους, τους ηλικιωμένους και τους ανοσοκατασταλμένους, αυτοί οι παθογόνοι παράγοντες μπορεί να αποβούν απειλητικοί για τη ζωή.
Η παστερίωση του ζωικού γάλακτος έχει υιοθετηθεί ευρέως ως βασικό μέτρο δημόσιας υγείας, σύμφωνα με τον FDA.
«Υπάρχουν πολλοί κίνδυνοι στην κατανάλωση ωμού γάλακτος», δήλωσε η δρ. Uzma Syed, ειδική λοιμωξιολόγος και μέλος της Infectious Diseases Society of America, στο The Post.
«Η παστερίωση έχει επιτρέψει την ασφαλή κατανάλωση γάλακτος για δεκαετίες.»
Σε μια μελέτη του 2023, το 4,4% των Αμερικανών ανέφερε ότι κατανάλωσε ωμό γάλα το προηγούμενο έτος, ενώ το 1% δήλωσε ότι το πίνει εβδομαδιαία.
Ο υπουργός Υγείας και Ανθρωπίνων Υπηρεσιών RFK Jr. ανήκει στην αυξανόμενη ομάδα οπαδών του ωμού γάλακτος, δηλώνοντας το 2022 ότι είναι το μόνο που πίνει.
Προς το παρόν, έως και 30 πολιτείες, συμπεριλαμβανομένης της Καλιφόρνια, επιτρέπουν την πώληση ωμού γάλακτος. Αντίθετα, οι υπόλοιπες 20 πολιτείες απαγορεύουν την πώληση ωμού γάλακτος με διάφορους τρόπους, αλλά όλο και περισσότερες νομοθετικές αρχές εξετάζουν ξανά το θέμα: η Αϊόβα νομιμοποίησε την πώληση ωμού γάλακτος το 2023, ενώ το Ιλλινόις επανέφερε πέρσι νομοσχέδιο για επέκταση των πωλήσεων.
Στην Καλιφόρνια, το ωμό γάλα ρυθμίζεται από το California Department of Food and Agriculture (CDFA), το οποίο απαιτεί από τις γαλακτοκομικές μονάδες να αποκτούν άδεια και να περνούν ελέγχους υγιεινής της μονάδας και της εμφιάλωσης. Το ωμό γάλα πρέπει να πληροί αυστηρά όρια βακτηριακού και κυτταρικού φορτίου και να φυλάσσεται σε θερμοκρασία 45°F (περίπου 7°C) ή χαμηλότερη. Επιπλέον, οι αγελάδες πρέπει να εξετάζονται ετησίως για βρουκέλλωση και φυματίωση.